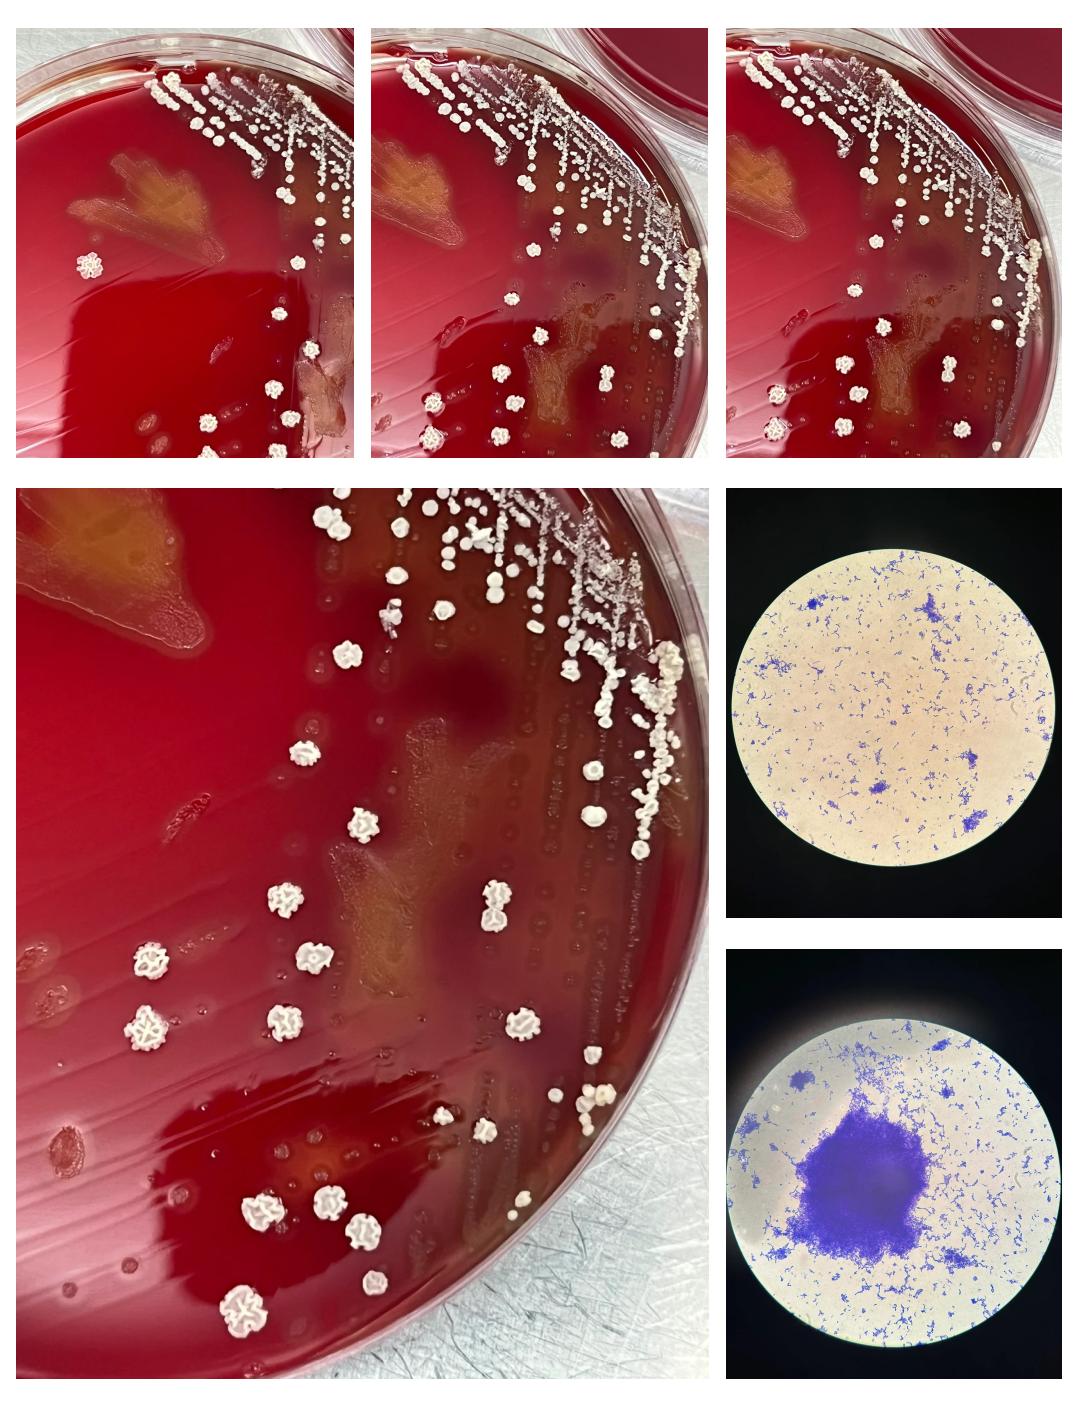
什么原因引起的链球菌感染

第一次可以进2根手指吗
三恐惧程度最轻部分成功但持续疼痛型核心表现可接受12根手指插入,但无法完成性交或性交时疼痛明显但能勉强进行疼痛可能集中于阴道入口浅部疼痛或深部如子宫颈刺激可能原因技术问题性交姿势不当导致阴道壁受压,或伴侣尺寸不匹配心...
什么原因引起的链球菌感染
1、新生儿B族链球菌感染主要由垂直传播医源性感染接触感染和定植四种途径引起,具体如下垂直传播是新生儿感染的主要途径孕妇在分娩过程中,若阴道或直肠定植B族链球菌,细菌可通过产道上行感染胎儿尤其在胎膜早破或产程延长时,胎...
宫外孕用验孕棒能测出来吗?..
本文目录一览: 1、宫外怀孕能用验孕棒测出来吗?怀孕一一个月怎么打掉最安全 宫外怀孕能用验孕棒测出来吗?怀孕一一个月怎么打掉最安全...
伤口流水不结痂(你会使用创可贴吗)
创可贴是家庭“小医生”,医生提醒大家使用时应严格掌握适应症。本报记者 赵永辉摄□本报记者 周 丽 受访专家:石家庄市第一医院骨四科主任范金鹏石家庄市第二医院药剂科主任刘恩甫近日,苏州一个四岁小女孩,手指受伤用创可贴包...
肌酐高是怎么回事?(血液检查肌酐高是咋回事结合肾功能饮食)
血液检查发现肌酐高,不一定就是肾脏出了大问题,它可能是生理因素暂时影响,也可能是肾脏功能异常的信号,核心是结合近期饮食、用药、运动量以及肾功能其他指标(如估算肾小球滤过率) 综合判断,避免因单一指标异常就盲目恐慌或忽...

京公网安备11000000000001号
京公网安备11000000000001号 京ICP备11000001号
京ICP备11000001号